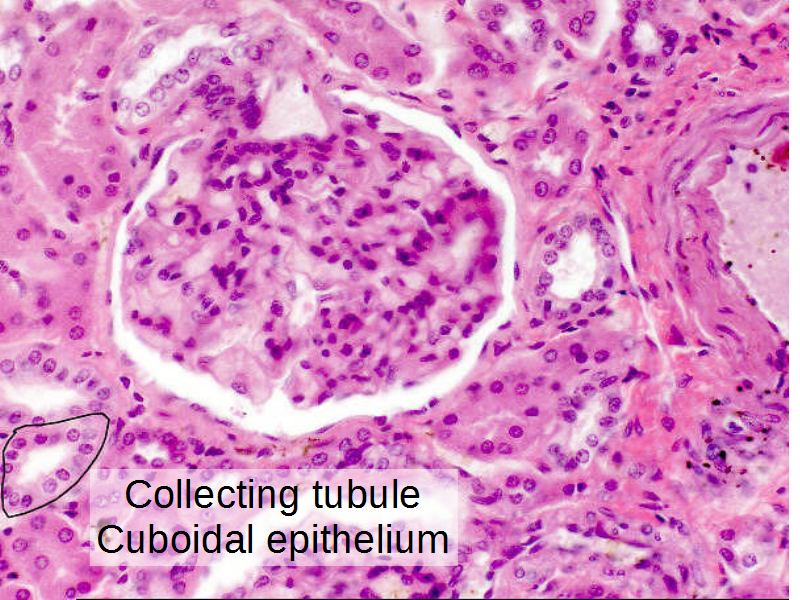
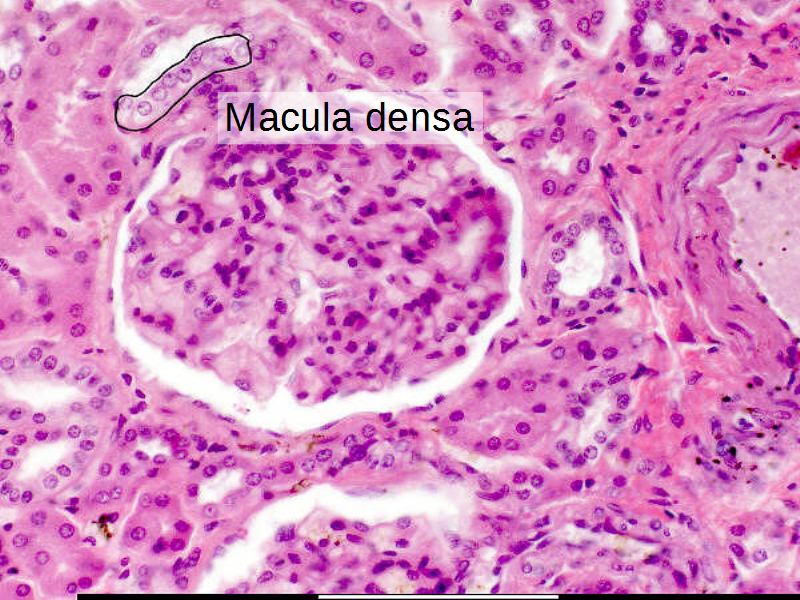
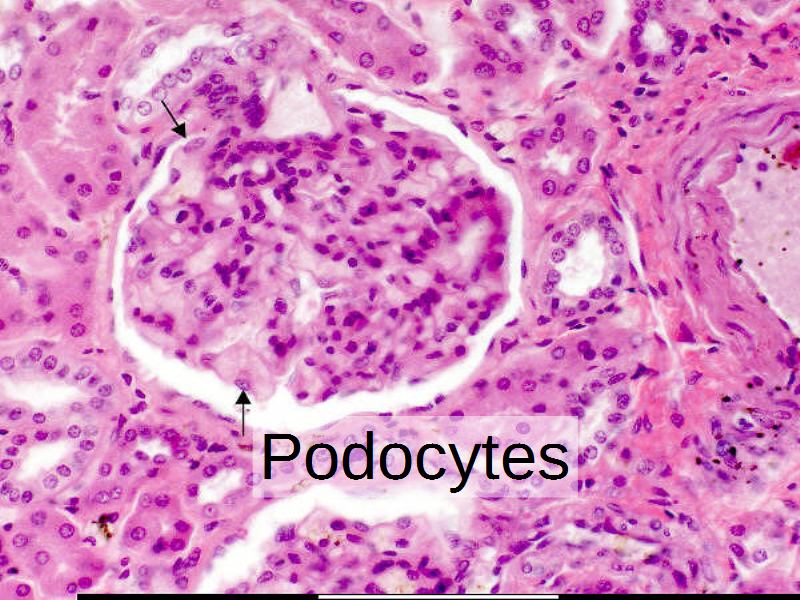
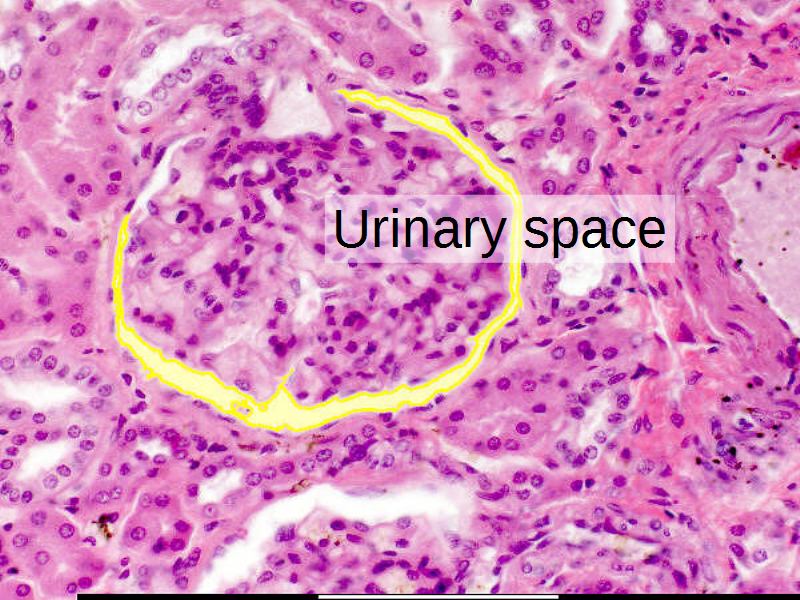
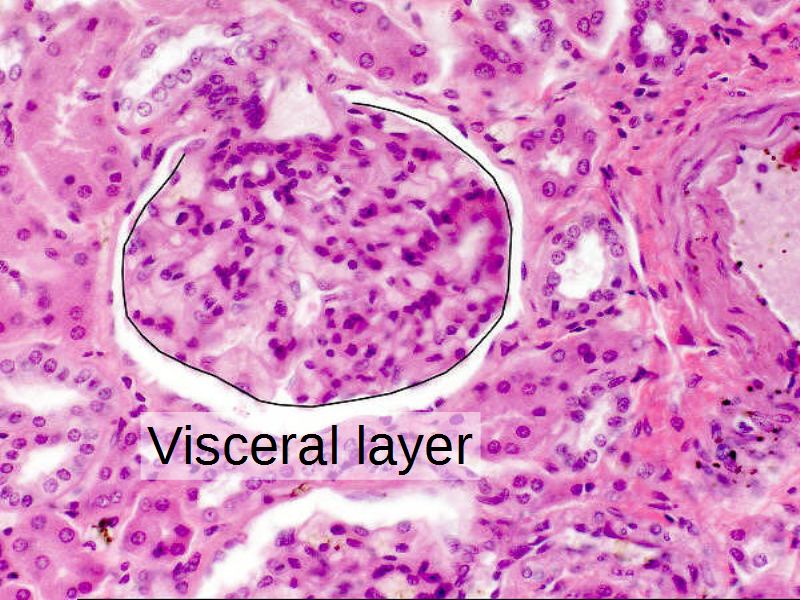
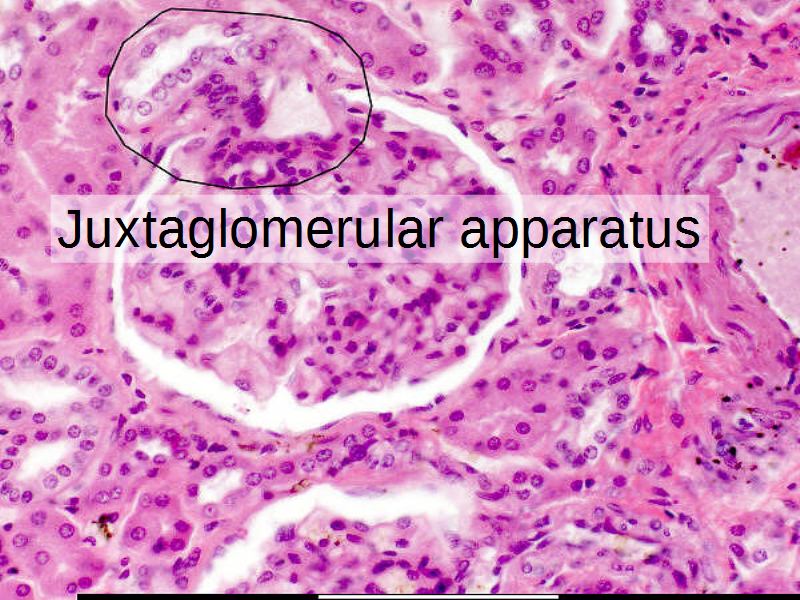

- esc key shows all the slides
- arrows left right advance the slide
- or click on the bottom right icons
- mobile device swipe left right
- ? gives instant help
Liver
Urinary system
Respiratory system
Skin
- Have a pen & paper ready
- Answer every question
- Mark your answer after answering
- Elaborate on each answer
- Add relevant clinical content
- If you have trouble, ask
Adam Virgile

and
Infectious Diseases

Your patient?



Why Barriers?








Making Sense
Systematically
forRetention
Understanding
Long Term
Objectives
What you need to knowTasks
Exercises to reach the objectives





Dissecting the slides
- What am I looking at?
- What can I identify?
- What else looks like this?
- Where is Up, Down, Inside, Outside?
- What is the magnification?
- Which items are larger/smaller?
- What do I need to look up?
- Can I add anything else?
Generic Approach
For all topics
Ask yourself:- Where is it?
- What does it do?
- How does it work?
Expand to make connections with:
- Anatomy
- Physiology
- Pathology
- Pharmacology
Feedback
As I receive questions, I will add some notes here to clarify. Go down to see the content.VVVVvVVV
Arteries, veins and bile ducts
Arteries has small round lumens, with relatively thick walls. Veins has large irregular lumens, with relatively thin walls. Both have endothelium, but it bulges more in arteries. If you see distinct cuboidal epithelium, it is most likely a bile duct.Portal vein vs Central vein
The portal vein is part of the portal triad. It has an associated artery and bile duct. The central vein has no other structures around it, and the endothelium is indistinct. You can most the times also see the sinusoids opening up into the central vein.



| Lymphoid system | Liver | Kidney | |
|---|---|---|---|
| Structures | |||
| Substances | List all substances moving through the structure. | ||
| Paths | List the path these substances take through the structure. | ||
| Slides | Correlate with the microscopic structure. | ||


Cells + Tissues
makeOrgans
which containsStructures
each having one or moreFunctions







Liver Structure
3 Views of the HistologyThink in general...
Think about gross morphology as seen during dissection...
Stuff in
and
Stuff out...
What stuff?
...And using scholarly languageBlood in: Arterial and Venous
Blood out: Venous
Bile out
Arterial - from where?
Venous - from where?
Blood out:
Venous - going where?
Bile out going where



Arteries?
Veins?
Bile ducts?
Lymph vessels?
Arteries - no
Veins - no
Bile ducts - no
Lymph vessels - no
Where do we find these structures?
Arteries - no
Veins - no
Bile ducts - no
Lymph vessels - no
Where do we find these structures?
Portal triad contains these structures.



Let's add these to our diagram...
ps: there is a lymph vessel as well











Detoxification
Metabolism of nutrients
Production of bile
Detoxification
Metabolism of nutrients
Production of bile
Where does bile production take place?
Where does the bile go to?



Blood flow
What happens
to blood
going
into the liver?
Blood flow
From hepatic artery and vein
Mix
Flow towards the central vein



Blood flow
What are the clinical implications of the histological morphology?











Traumatic events in the liver
Illustrate the damaged area of Liver acinusVisible histologically
Caused By Various Agents / Diseases
- Describe the mechanism
- Identify and explain the area
- Indicate zones of damage on a sketch
- Correlate with slide










Lymphoid Tissue
New parchmentSharpen those quills
Fire the neurons
| Lymphoid system | Liver | Kidney | |
|---|---|---|---|
| Structures | |||
| Substances | List all substances moving through the structure. | ||
| Paths | List the path these substances take through the structure. | ||
| Slides | Correlate with the microscopic structure. | ||
| Lymphoid system | |
|---|---|
Primary
|
Secondary
|
Not all have a capsule
But all have Lymphoid follicles
etc
| Lymphoid tissue | |
|---|---|
Tissue/Organ:
|
Structures:
|
- Capsule = ?
- Cortex-Medulla = ?
- Germinal Centers?
- Primary = ?
- Secondary = ?
- Lobulation = ?
- Cells = ?
- Capsule = No
- Cortex-Medulla = ?
- Germinal Centers?
- Primary = ?
- Secondary = ?
- Lobulation = ?
- Cells = ?
- Capsule = No
- Cortex-Medulla = No
- Germinal Centers?
- Primary = ?
- Secondary = ?
- Lobulation = ?
- Cells = ?
- Capsule = No
- Cortex-Medulla = No
- Germinal Centers?
- Primary = No
- Secondary = ?
- Lobulation = ?
- Cells = ?
- Capsule = No
- Cortex-Medulla = No
- Germinal Centers?
- Primary = No
- Secondary = Yes
- Lobulation = ?
- Cells = ?
- Capsule = No
- Cortex-Medulla = No
- Germinal Centers?
- Primary = No
- Secondary = Yes
- Lobulation = No
- Cells = ?
- Capsule = No
- Cortex-Medulla = No
- Germinal Centers?
- Primary = No
- Secondary = Yes
- Lobulation = No
- Cells = B, T, Fibroblasts, Macrophages





- Capsule = Strat Sq Epithelium
- Cortex-Medulla = No
- Germinal Centers = Yes
- Lobulation = Infolding from SSE+CT
- Cells = M, B, T-cells

- Capsule = Yes
- Cortex-Medulla = Yes
- Germinal Centers = No
- Lobulation = Cortex, Yes
- Cells = Epithelial, Hematopoietic, Accessory

- Capsule = Yes + Serosa+Mesothelium
- Cortex-Medulla = No
- Germinal Centers = Yes
- Lobulation = No, CT trabeculae
- Cells = RBC, Platelets, T, B, macrophages



Kidney
Next A4 pageKidney
- Make a line diagram, using supplied labels.
- Label the colour slides.
- Annotate the two diagrams
- Complete the diagram:
- Events in each part of the nephron
- Stimulate / Inhibit

Trace the air flow of respiratory system starting with the nostrils.
What path does a molecule of oxygen take to reach the blood?
What sights will it see along the way?
- Outside air
- ??
- ...
- Toes

- List complete
- With layers
- And cells
- And function of each
- By studying and labelling images


What cells are present?
- Goblet cells
- Basal cells
- Ciliated columnar cells
- Unciliated columnar cells















Skin
Consider a needle penetrating skin.
Describe the layers.
Up to and including the vein.

Which layers of cells are penetrated?
What do they look like?
What is the function of each layer?
What is the function of each type of cell?









The End
Save Document
- Click the link above
- Print to PDF
Works best using Google Chrome
Others Browser YMMV